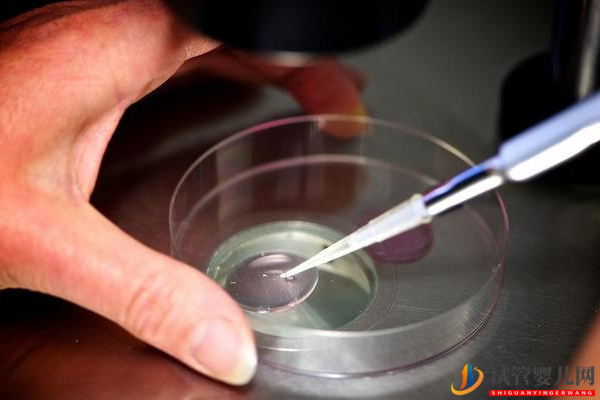
巨細胞病毒陽性不能直接做試管(圖2)

?
欧美日韩国产在线播放网站|
亚洲色图50p|
在线视频第一页|
女人让男人操自己视频在线观看|
欧美日韩综合在线|
久久精品女同亚洲女同13|
丰满的护士2在线观看高清|
91福利精品视频|
国产+高潮+白浆+无码|
av手机在线观看|
日韩免费在线观看|
永久免费看片视频教学|
国产视频一区二|
中文字幕在线亚洲|
国产免费a视频|
中文有码一区|
欧美性视频在线|
天天干,夜夜爽|
亚洲一区二区毛片|
久久久久天天天天|
jizz.www|
中文字幕第一区|
www.色就是色|
gogo在线高清视频|
欧美乱妇15p|
午夜国产福利视频|
国产suv精品一区|
久久久在线视频|
色窝窝无码一区二区三区成人网站
|
国产日韩欧美二区|
女同互添互慰av毛片观看|
国产欧美日韩不卡免费|
九九九在线观看视频|
超碰在线caoporen|
日韩女优毛片在线|
国产一级片久久|
国产亚洲电影|
国产欧美精品一区二区三区介绍|
欧美jizzhd精品欧美满|
成人免费毛片嘿嘿连载视频|
日韩欧美不卡在线|
日本在线免费|
精品欧美一区二区三区精品久久|
国产一级做a爱免费视频|
久久不见久久见免费视频7|
日本精品久久中文字幕佐佐木|
影音先锋中文字幕影院|
国产精品影视网|
欧美中文字幕在线观看视频|
国产h在线观看|
777色狠狠一区二区三区|
免费在线观看一级片|
国内成人精品|
91夜夜揉人人捏人人添红杏|
九九热在线视频观看|
国产精品久久久久四虎|
永久免费看片在线观看|
久久99国产精品二区高清软件|
欧美成人亚洲成人日韩成人|
亚洲色图狠狠干|
国产精品77777|
春日野结衣av|
欧美卡一卡二|
伊人久久久久久久久久久久久|
国产乱人乱偷精品视频a人人澡|
亚洲中午字幕|
综合色婷婷一区二区亚洲欧美国产|
香蕉国产在线|
在线综合视频播放|
亚洲伊人成人网|
激情综合在线|
亚洲美女搞黄|
国产美女性感在线观看懂色av|
欧美一区二区福利在线|
中文字幕亚洲乱码熟女1区2区|
激情视频一区二区三区|
四虎一区二区|
国产高清免费av在线|
欧美刺激午夜性久久久久久久|
加勒比在线一区|
麻豆精品网站|
阿v天堂2018|
av资源网在线播放|
日韩一区在线视频|
日本久久网站|
欧美激情一区二区三区不卡|
性囗交免费视频观看|
国产精品香蕉|
91天堂在线观看|
春暖花开亚洲|
欧美影院午夜播放|
99精品在线播放|
鲁大师成人一区二区三区|
av影院在线播放|
神马午夜伦理不卡
|
国产精品一区二区a|
五十度飞在线播放|
在线不卡一区二区|
欧美国产一级片|
免费久久精品视频|
精品一卡二卡三卡|
欧美国产日韩电影|
日韩av成人在线观看|
极度色播免费播放视频|
欧美视频二区36p|
国产精品第108页|
99riav国产精品|
免费看欧美黑人毛片|
欧美男男激情videos|
亚洲 日韩 国产第一|
黄色免费视频在线观看|
精品国产老师黑色丝袜高跟鞋|
劲爆欧美第一页|
国产一区成人|
北条麻妃69av|
久久三级毛片|
国产精品自拍小视频|
国产福利电影在线观看|
91精品国产综合久久精品图片
|
国产在线精品视频|
黄色a级三级三级三级|
韩国女主播一区二区三区|
国产精品18毛片一区二区|
日韩电影在线观看完整版|
日韩激情视频在线播放|
严阵以待中文社区|
亚洲精品乱码久久久久久|
日本高清一二三区|
最新国产乱人伦偷精品免费网站|
欧美成人精品免费|
播放一区二区|
国产一区香蕉久久|
午夜成人影视|
亚洲一区第一页|
国产免费一级|
日韩欧美亚洲成人|
中文字幕精品在线观看|
成人免费视频caoporn|
人妻少妇精品视频一区二区三区|
欧美残忍xxxx极端|
波多野结衣与黑人|
国产91在线精品|
亚洲va久久久噜噜噜久久天堂|
四虎精品在永久在线观看
|
欧美丰满一区二区免费视频
|
91网站视频在线观看|
女女互磨互喷水高潮les呻吟|
午夜精品久久久久99热蜜桃导演
|
国产成人亚洲精品播放器下载|
精品久久在线播放|
中文资源在线播放|
26uuu亚洲|
人妻无码一区二区三区免费|
国产欧美午夜|
日本在线观看视频一区|
欧美日韩高清|
日本大胆人体视频|
自拍偷拍亚洲|
精品在线视频一区二区三区|
1769免费视频在线观看|
欧美一级淫片播放口|
fc2人成共享视频在线观看|
精品视频久久久久久|
九色蝌蚪国产|
欧美午夜电影在线播放|
成人无码一区二区三区|
亚洲免费观看高清完整版在线|
国产欧美日韩另类|
高清不卡一二三区|
亚洲天堂最新地址|
日韩黄色在线观看|
日本美女视频网站|
国产精品jizz在线观看美国|
免费日韩中文字幕|
亚洲免费福利一区|
www.国产在线视频|
成人动态视频|
亚洲国产日韩欧美|
福利一区和二区|
久久久久久九九九九|
美女搞黄视频在线观看|
亚洲a成v人在线观看|
黄色网页在线观看|
国产精品第1页|
国产一区二区三区不卡在线|
久久久久久久久亚洲|
蜜桃传媒在线|
欧美大成色www永久网站婷|
99reav2|
中文字幕一精品亚洲无线一区|
国内福利视频|
日韩成人中文字幕|
免费看涩涩视频软件|
亚洲成人黄色网|
中国jizz妇女jizz妇女|
日韩一级大片在线|
国产成人禁片免费观看|
91精品国产手机|
国产欧美日本亚洲精品一4区|
欧美高清激情brazzers|
欧美最猛黑人xxxx黑人猛交3p|
欧美色视频一区|
亚洲综合爱爱久久网|
欧美日韩在线播|
最近中文字幕大全中文字幕免费|
欧洲国产伦久久久久久久|
juy有坂深雪中文字幕|
欧美亚洲日本国产|
中文字幕在线久热精品|
在线电影一区二区三区|
久久er这里只有精品|
日韩网站在线看片你懂的|
2023国产在线观看|
亚洲国产黄色片|
被弄出白浆喷水了视频|
国产亚洲精品一区二555|
羞羞网站在线观看入口免费|
www.久久久久|
少妇激情av一区二区三区|
美日韩精品免费视频|
中文字幕视频免费在线观看|
97精品视频在线播放|
91在线看黄|
国产区精品在线观看|
爱啪啪综合导航|
久久久av水蜜桃|
日韩欧国产精品一区综合无码|
在线精品日韩|
欧美激情15p|
成年人免费大片|
欧美另类综合|
国产高清成人久久|
久久国产精品露脸对白|
男人操女人的视频网站|
久久免费午夜影院|
中文字幕第一页在线播放|
亚洲成人福利片|
日本1区2区3区视频|
欧美一区二区三区免费|
青青草娱乐视频|
日韩一区二区福利|
欧美视频综合|
成人黄色大片在线免费观看|
性欧美freesex顶级少妇|
日韩精品久久一区|
欧美在线导航|
一级做a免费视频|
久久福利一区|
熟女少妇a性色生活片毛片|
久久综合色8888|
国产一区二区三区成人|
色av成人天堂桃色av|
国产人成精品|
国产亚洲欧洲高清一区|
天堂av在线资源|
成人激情视频在线|
国产福利亚洲|
在线观看日韩羞羞视频|
国产在视频线精品视频www666|
男女视频在线观看网站|
久久国产精品无码网站|
久久高清免费视频|
一级日本不卡的影视|
影音先锋中文字幕在线观看|
亚洲电影免费观看高清完整版在线|
黄色三级在线观看|
日本亚洲欧洲色|
中文在线资源|
亚洲精品少妇一区二区|
综合一区二区三区|
免费看黄色av|
国产日产欧美一区二区视频|
成人久久久精品国产乱码一区二区
|
精品三级av|
91小视频网站|
久久精品国产精品亚洲精品|
成人精品免费在线观看|
午夜日韩在线观看|
国产精品久久久高清免费|
色天天综合狠狠色|
日本福利在线|
欧美午夜免费|
日韩精品2区|
波多野结衣办公室33分钟|
2023国产精品自拍|
成人午夜视频一区二区播放|
精品国产凹凸成av人导航|
色播在线视频|
51精品国产人成在线观看|
亚洲国产精品免费视频|
一级黄色录像在线观看|
国产真实乱偷精品视频免|
中文字幕欧美在线观看|
制服丝袜成人动漫|
特黄特黄的视频|
91深夜福利视频|
99香蕉久久|
色哟哟免费视频|
99久久国产免费看|
免费观看的毛片|
亚洲男人的天堂在线播放|
91青青在线视频|
深田咏美在线x99av|
你懂的一区二区|
青青操视频在线播放|
五月综合激情网|
xxx在线视频|
国产精品扒开腿做|
国内精品视频|
人妻换人妻仑乱|
久久综合久久鬼色|
男人的天堂va|
久久天堂av综合合色|
h片精品在线观看|
欧美日韩福利在线|
久久午夜av|
一区二区乱子伦在线播放|
欧美一区二区三区的|
天堂v视频永久在线播放
|
国产精品麻豆久久|
久久精品亚洲a|
亚洲1区2区3区视频|
eeuss影院130020部|
国产欧美精品久久久|
牛牛影视一区二区三区免费看|
日韩综合第一页|
亚洲国产高清aⅴ视频|
国产青草视频在线观看视频|
91国产精品视频在线|
91精品国产一区二区在线观看|
五月天婷婷在线观看视频|
91啪九色porn原创视频在线观看|
亚洲激情丁香|
欧美理论电影在线观看|
桃花岛tv亚洲品质|
日韩中文字幕a|
久久综合九色综合久久久精品综合|
日本久久天堂|
亚洲91av视频|
深夜福利一区二区三区|
一本加勒比波多野结衣|
亚洲视频中文字幕|
成片免费观看|
91免费看国产|
不卡av一区二区|
久久久久亚洲AV|
91.com视频|
av网站在线免费观看|
国产美女作爱全过程免费视频|
蜜臀av一区二区|
亚洲第九十九页|
久久九九精品99国产精品|
嫩草伊人久久精品少妇av杨幂|
亚洲国产欧美日韩在线|
国产精品二三区|
jizz日本18|
国产精成人品localhost|
一区二区电影|
神马久久久久久久|
亚洲精品动漫久久久久|
日本高清成人vr专区|
免费观看成人网|
91免费看`日韩一区二区|
国产麻豆精品入口在线观看
|
盗摄系列偷拍视频精品tp|
1024在线看片|
在线日韩av片|
精品美女视频在线观看免费软件|
蜜臀av.com|
国产福利一区二区三区视频在线|
中文字幕jux大岛优香|
69久久夜色精品国产69|
国产精品流白浆在线观看|
午夜激情视频在线播放|
欧洲一区二区三区免费视频|
国产一级二级三级在线观看|
日韩精品综合在线|
成人中文字幕电影|
国产红桃视频|
亚洲一区二区三区成人在线视频精品|
国产精品99久久|
高潮毛片又色又爽免费
|
久久久久久久久免费看无码|
欧美日韩精品在线播放|
水莓100国产免费av在线播放|
午夜久久久久久久久久久|
国产成人在线视频网址|
久久精品国产麻豆|
91在线播放国产|
欧美激情第二页|
国产男男gay网站|
九色精品免费永久在线|
成人动漫视频|
久久久久香蕉视频|
日韩精品亚洲视频|
欧美影视资讯|
国产一区二区三区四区五区六区|
欧美吻胸吃奶大尺度电影|
国产素人视频在线观看|
美女少妇一区二区|